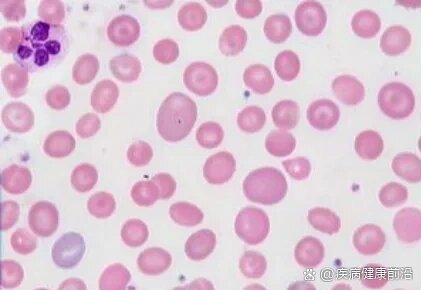
大细胞性贫血(基础解析)

大细胞贫血

大细胞性贫血(基础解析)
图片尺寸421x290
大细胞性贫血
图片尺寸651x434
大细胞贫血伴血小板减少症,叶酸缺乏症,维生素b12缺乏症的显微镜图像.
图片尺寸800x794
"贫血"知多少
图片尺寸630x487
贫血不是小事!这份食方帮你改善贫血问题
图片尺寸1080x786
贫血是指人体外周血红细胞容量减少,低于 - 抖音
图片尺寸3508x3413
中医科普第68讲:贫血
图片尺寸969x684
从双手看出你是否有贫血
图片尺寸1080x810
巨幼细胞贫血骨髓象
图片尺寸1280x1706
巨幼细胞贫血是由维生素b12和(或)叶酸等缺乏,使细胞dna合成障碍,导致
图片尺寸640x525
不同寻常的大细胞性贫血探因之路
图片尺寸800x526
血管堵塞的诱因有哪些
图片尺寸500x375
一例大细胞性贫血病例的探索历程
图片尺寸660x400
一例胃癌胃切除老年患者巨幼细胞性贫血临床检验案例回顾分析
图片尺寸902x902
一种因叶酸或维生素b12缺乏导致的贫血类型,其特点在于红细胞体积增大
图片尺寸1281x1280
红细胞生理与贫血
图片尺寸1280x1705
贫血记忆 br>贫血的形态学分类 br>大细胞性贫血……巨幼细胞性贫血
图片尺寸1280x1706
你的身体可能是缺铁了|贫血|血红素|补铁|铁元素_网易订阅
图片尺寸660x406
再生障碍性贫血出现发烧发热应该怎么办?
图片尺寸2560x1524
医学生笔记|巨幼细胞贫血表现🔆 ⚠️注意: 🔆b12缺乏➡
图片尺寸959x1280